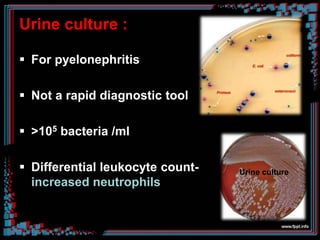
Urine culture :
 For pyelonephritis
 Not a rapid diagnostic tool
 >105 bacteria /ml
 Differential leukocyte count-
increased neutrophils
Urine culture

This document provides an overview of urinary tract infections (UTIs). It begins with definitions and terminology related to UTIs. It then discusses the classification, epidemiology, etiology, pathogenesis, risk factors, clinical presentation, diagnosis, treatment, and conclusions regarding UTIs. The document is intended as an educational seminar on UTIs and contains detailed information on various aspects of these common bacterial infections.